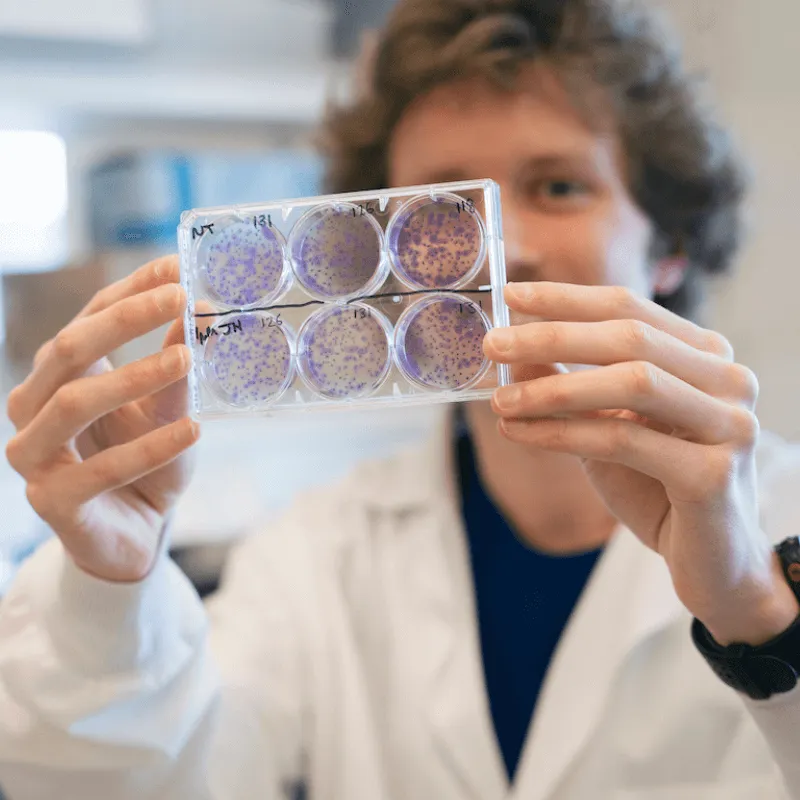

Your journey at the University of Vermont will be unique, tailored to meet your academic, professional, and personal goals. At UVM, you’ll join the ranks of people in every field with the courage, vision, global mindset, and ambition to effect lasting change.
Academic Experiences, Tailored to Your Path
The resources, partnerships, and network of a top-100 research university are yours to tap. With over 100 majors, our fields of study are broad and the intellectual pools are deep.
Choose an Area of Study Explore Research Opportunities












